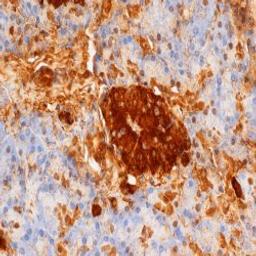
Staining of paraffin embedded human pancreas with Mouse anti Rat Insulin (5330-3369)
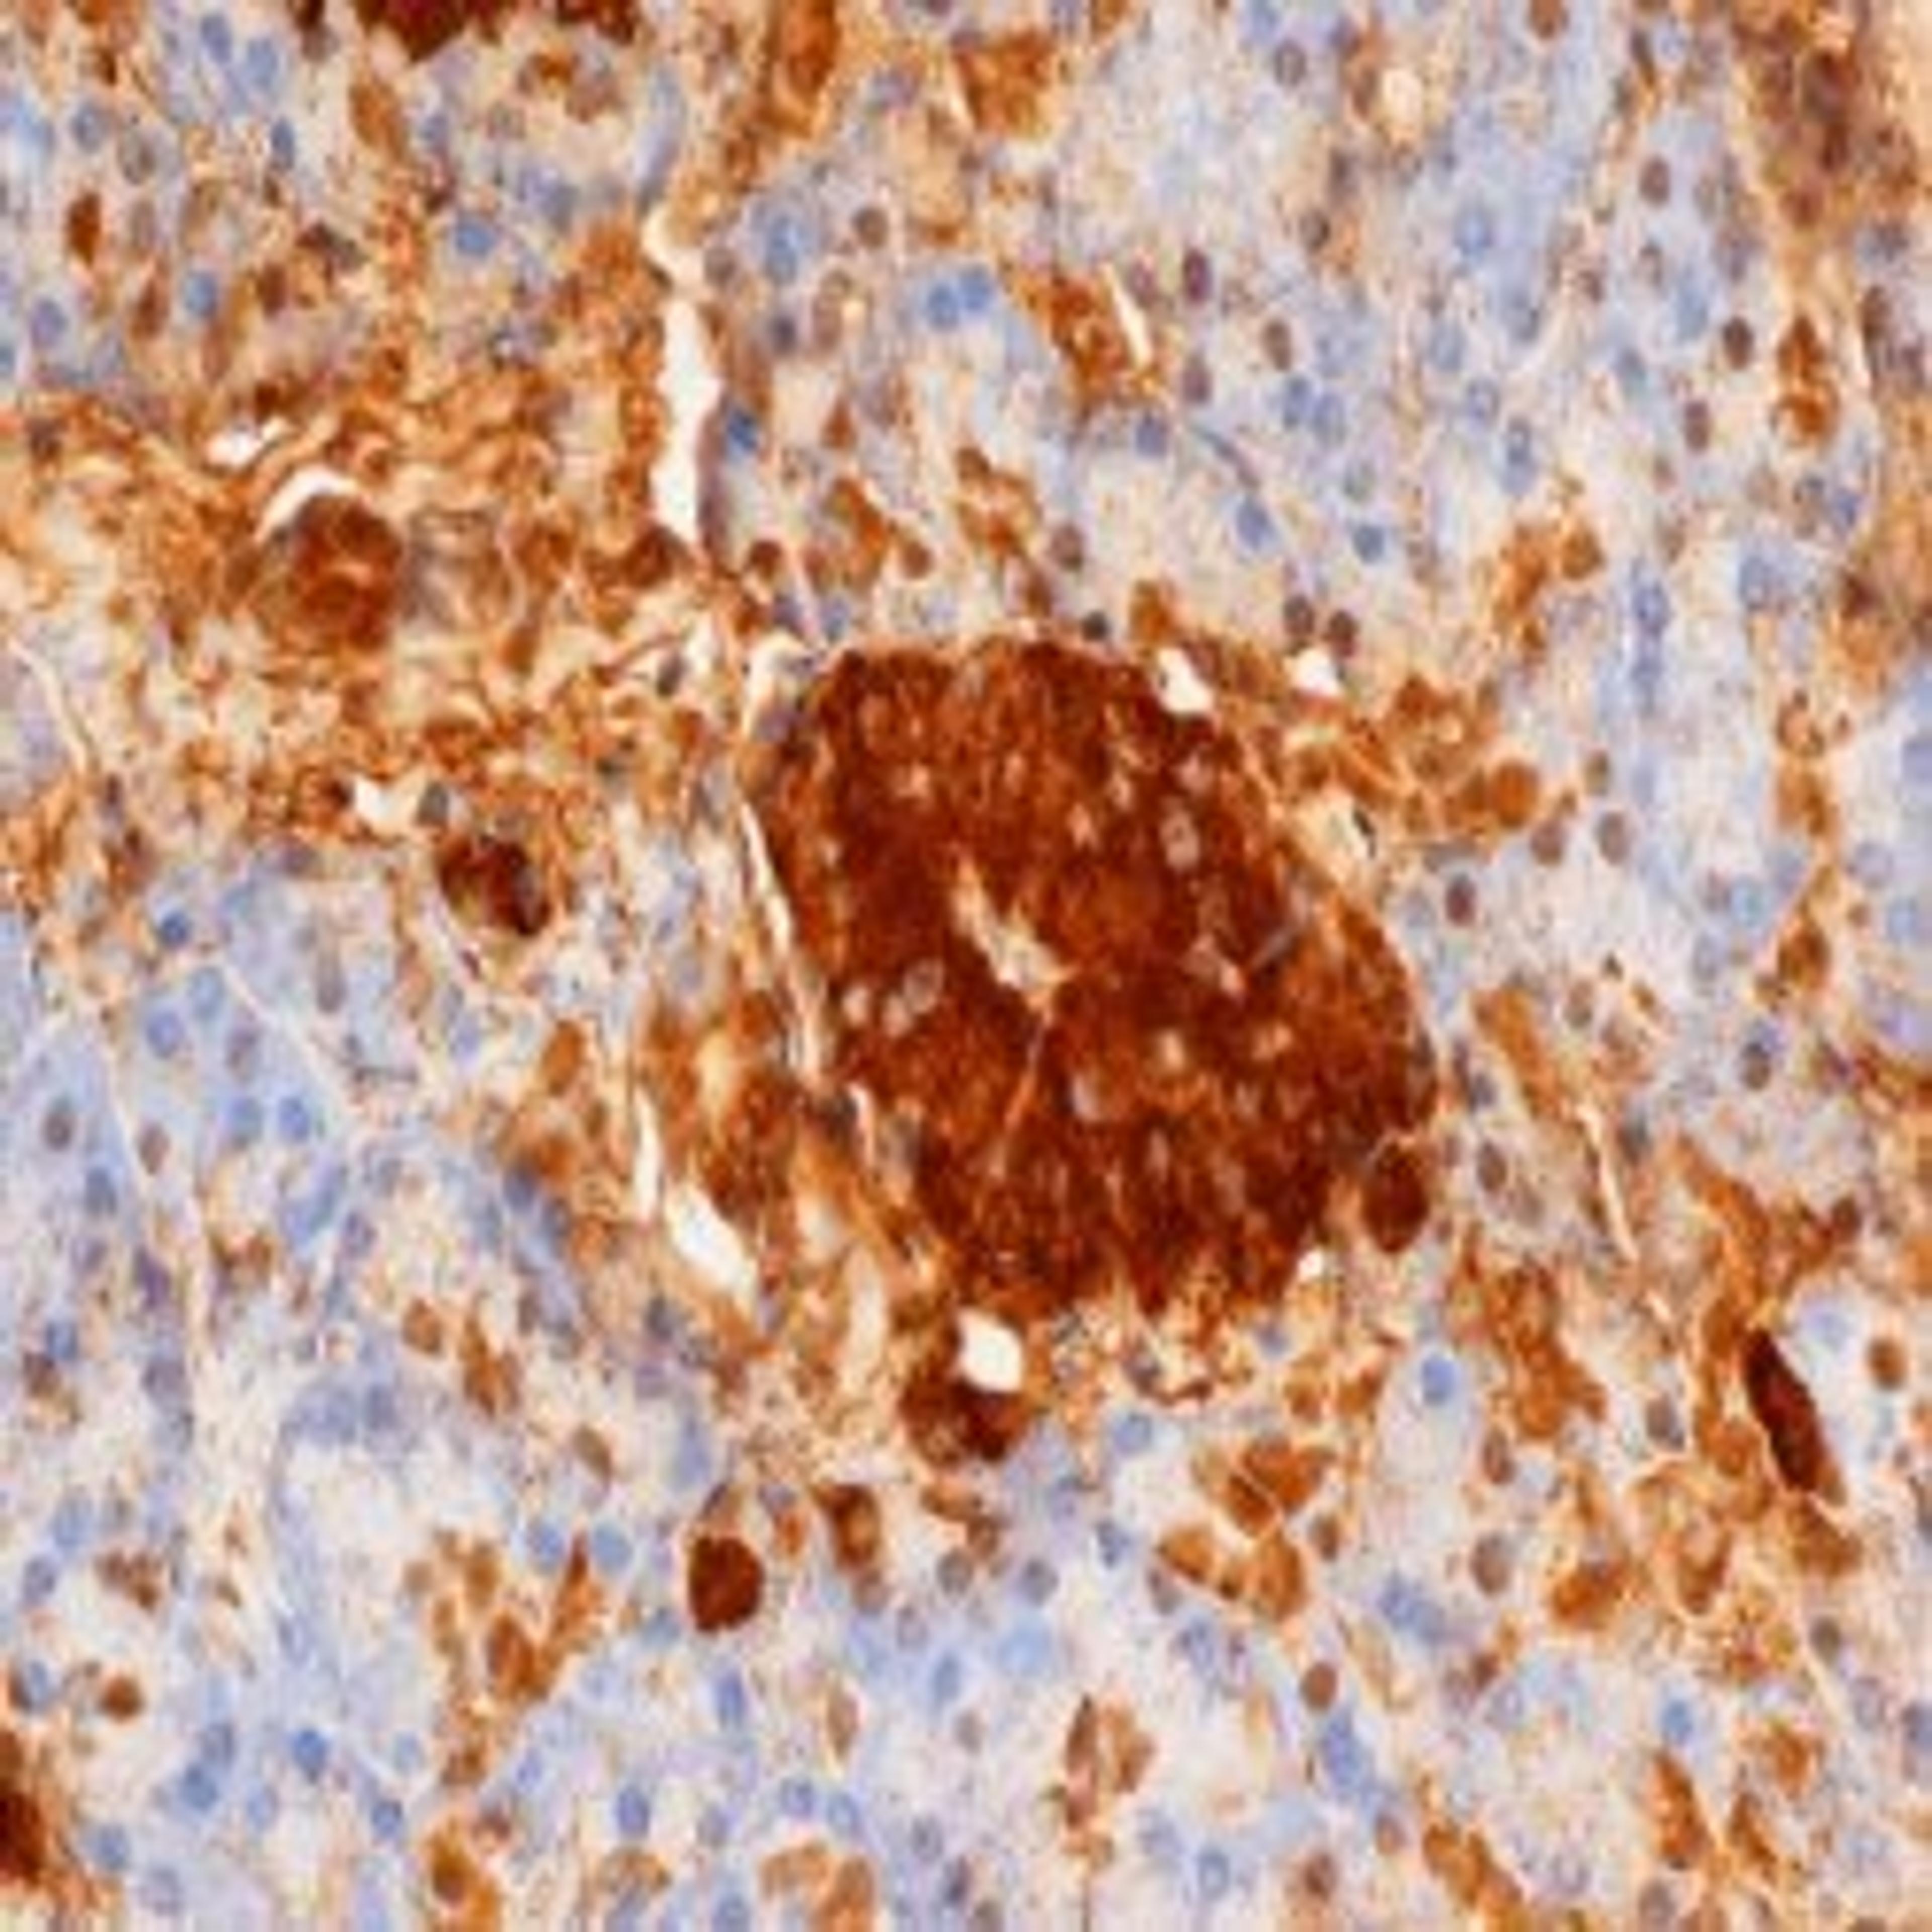
Staining of paraffin embedded human pancreas with Mouse anti Rat Insulin (5330-3369)

Product & ReviewsAntibodies
MOUSE ANTI HUMAN INSULIN/PROINSULIN
Product Details
- Cat. No.
- 5330-3369
- Type
- Primary Antibody
- Clonality
- Monoclonal
- Host
- Mouse

The supplier does not provide quotations for this antibody through SelectScience. You can search for similar antibodies in our Antibody Directory.
Description
Mouse anti Human Insulin/Proinsulin antibody, clone D3E7 (5B6/6) recognizes both insulin and proinsulin, but does not react with free C-peptide.
Biological Information
- Clonality: Monoclonal
- Host: Mouse
- Reactivity: Bovine, Human, Mouse, Pig (Swine), Rat
- Isotype: IgG1
Handling
- Quantity: 0.2 mg
- Storage: +4ºC, -20ºC if preferred
- Buffer: Phosphate buffered saline, 0.09% Sodium Azide
Applications
- ELISA (ELISA)
- Immunohistochemistry (Frozen Sections) (IHC (Fr))
- Immunohistochemistry (Paraffin-Embedded Sections) (IHC (P))